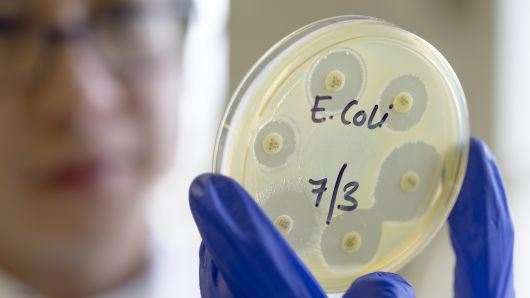
Bí ẩn dịch bệnh khiến 72 người ở Mỹ nhiễm bệnh

Bí ẩn dịch bệnh khiến 72 người ở Mỹ nhiễm bệnh
(PLVN) - Mới đây, Trung tâm Kiểm soát và Phòng ngừa dịch bệnh Mỹ (CDC) đang cảnh báo về một dịch bệnh bí ẩn có tên vi khuẩn E. coli là nguyên nhân khiến 72 người nhiễm bệnh, 5 bang của Mỹ.
Theo CNN, 5 bang có người nhiễm bệnh là Georgia (8 người), Kentucky (36 người), Ohio (5 người), Tennessee (21 người) và Virginia (2 người). Những người nhiễm khuẩn được ghi nhận vào ngày 2-29/3 và đây là một chủng E. coli đặc biệt. Bệnh nhân có độ tuổi trung bình là 17, trẻ nhất là 1 tuổi và cao nhất là 74 tuổi.
Sau 3 - 4 ngày nhiễm khuẩn, người bệnh bắt đầu bắt đầu đi tiêu chảy, có khi ra máu, bị sốt, dau bụng dữ dội, buồn nôn và ói mửa. Sau đó, hầu hết bệnh nhân đều khỏe hơn trong vòng sau 5 - 7 ngày tiếp theo, tuy nhiên bệnh có thể diễn biến xấu và một số trường hợp thậm chí đe dọa đến tính mạng. Rất may cho đến nay chưa có người thiệt mạng.
CDC vẫn chưa xác định được nguồn gốc, nguyên nhân gây ra sự lây lan của dịch bệnh này. Do vậy, CDC chưa đưa ra khuyến nghị người dân nên tránh sử dụng một loại thực phẩm cụ thể nào. Trong khi đó, các nhà khoa học nhận định rằng, khuẩn E.coli có thể ẩn chứa trong một món thực phẩm, một tiệm tạp hóa hay một nhà hàng nào đó.
Tuy nhiên, CDC lên tiếng cảnh báo, khuẩn E.coli có thể sẽ lây lan ra nhiều người. Do vậy, CDC đang phối hợp với Cục Quản lý thực phẩm và dược phẩm Mỹ (FDA), Cục kiểm tra an toàn thực phẩm (FSIS) thuộc Bộ Nông nghiệp Mỹ để điều tra vụ việc.